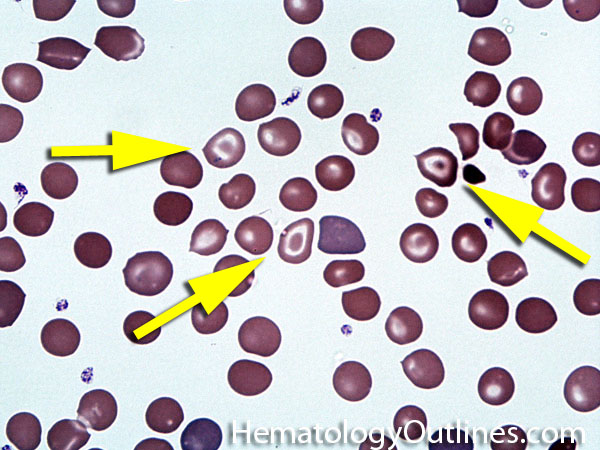
Target Cell

If you are having a hard time accessing the Haematologyetc page, Our website will help you. Find the right page for you to go to Haematologyetc down below. Our website provides the right place for Haematologyetc.

https://bingehomepagequiz.com
Bing News Quiz Test your knowledge with daily homepage quiz questions answers covering entertainment current events and more in this fun Bing quiz
https://bingquiz.org › bing-news-quiz
Test your knowledge of the latest headlines with 10 weekly questions on news politics science and pop culture Stay informed while having fun

https://weeklyquiz.net › bing-news-quiz
Play the Bing News Quiz a daily current events quiz covering today s top stories and headlines Try the Bing news quiz every day and see how much you really know about the news

https://bingnewsquiz.net
Bing News Quiz delivers fresh daily trivia on current headlines Enjoy Bing Homepage Quiz anytime with fun general knowledge questions and challenges online

https://bingquiz.net › today
Frequently Asked Questions About Today s Bing Quiz How many questions are in the Bing Homepage Quiz today The Bing Homepage Quiz for December 18 contains 3 multiple choice

https://popularnowonbing.com › bing-news-quiz
Stay updated with the latest world events and test your knowledge with the Bing News Quiz This daily online game allows you to play today and challenge yourself with breaking news

https://www.quizinside.com › bing-news-quiz
Discover the power of staying informed in a fun and engaging way with The Bing News Quiz This interactive quiz challenges your knowledge of the latest headlines from politics and

https://bingweeklyquiz.net
Each week you ll find fresh trivia across news science history sports entertainment and general knowledge plus short explanations so you learn something new without the fluff

https://www.geeksdigit.com › bing-news-quiz
The Bing News Quiz is a daily or weekly multiple choice quiz featured on Microsoft s Bing platform It consists of questions based on trending news stories global events pop culture
Thank you for visiting this page to find the login page of Haematologyetc here. Hope you find what you are looking for!